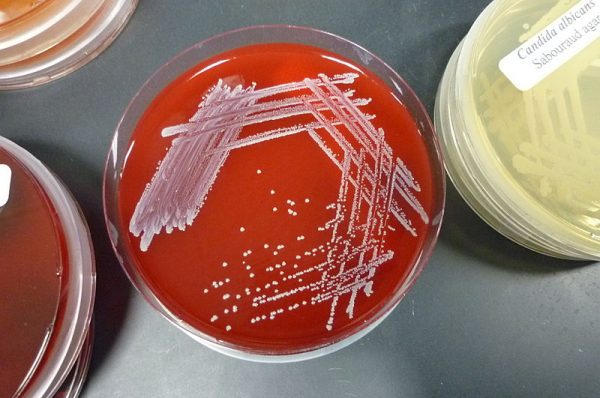

800px-S._epidermis_culture
Καλλιέργειες μυκήτων σε τρυβλία Πετρί. Είδη που ζουν στο δέρμα ανιχνεύονται και σε ορισμένους καρκίνους (Wikimedia Commons / CC BY-SA 3.0)
Spotlight
-

Οργή για τη δήλωση του Δ. Βαρτζόπουλου: «Η γυναικοκτονία έχει βιολογική βάση – Η γυναίκα είναι για να τίκτει
-

Σφυροκόπημα για την ιδιωτικοποίηση της Υγείας από την αντιπολίτευση - Ανέβηκαν οι τόνοι με Γεωργιάδη-Πολάκη
-

Πρεμιέρα στο Ιόνιο έκανε το τουρκικό ελικοπτεροφόρο Anadolu
-

Eurovision 2024: Βίντεο από την πρώτη πρόβα της Ελλάδας με τη Μαρίνα Σάττι
Ακολουθήστε το in.gr στο Google News και μάθετε πρώτοι όλες τις ειδήσεις

Αριθμός Πιστοποίησης Μ.Η.Τ.232442
Αριθμός Πιστοποίησης Μ.Η.Τ.232442